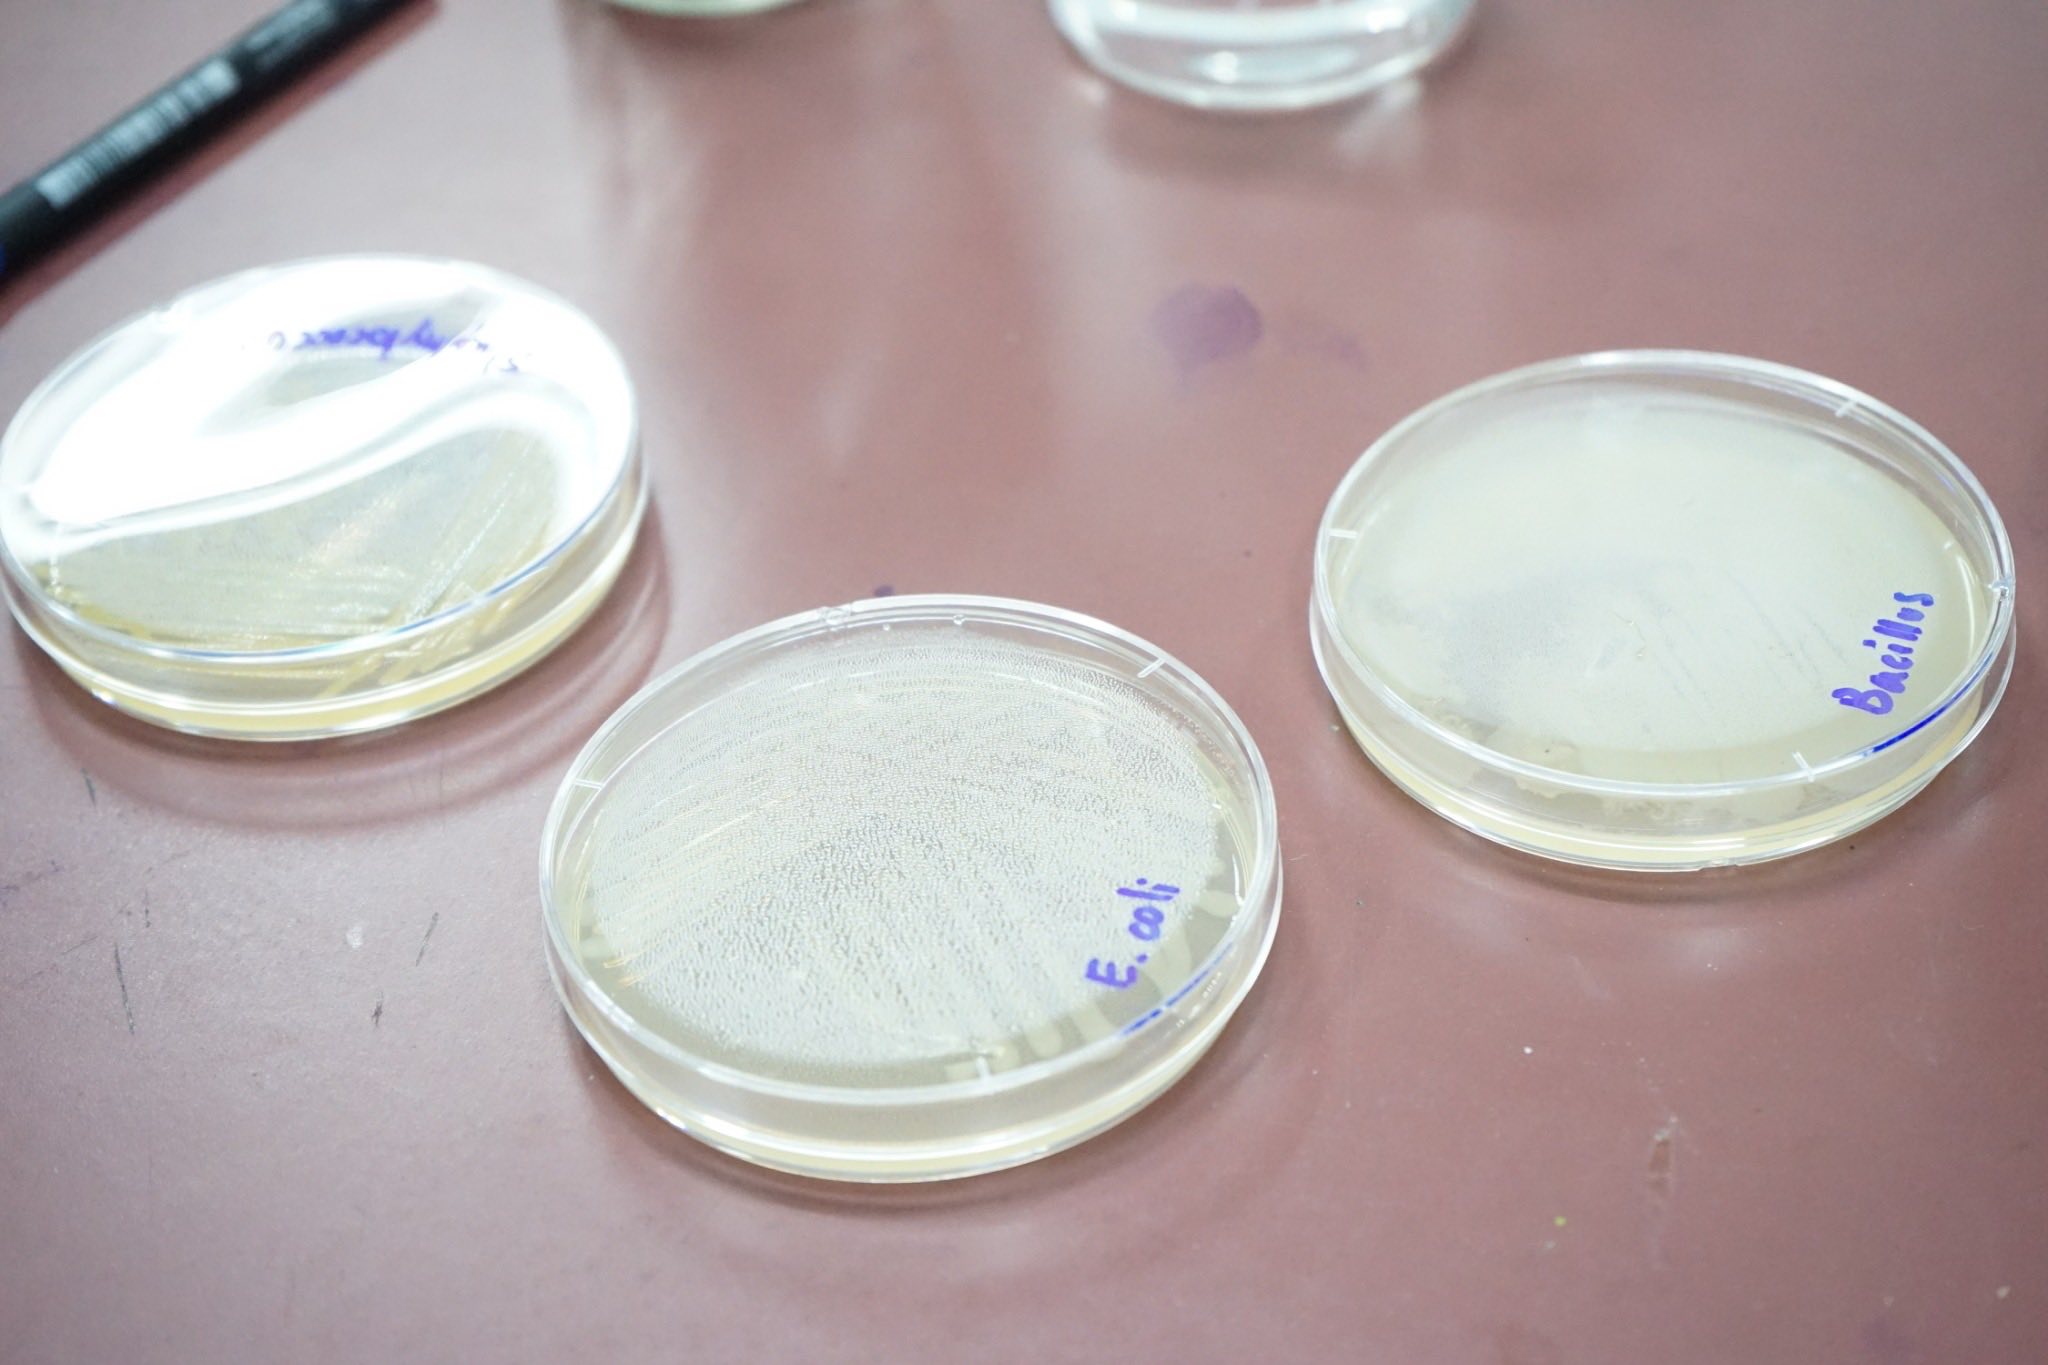

หลักสูตร วิทยาศาสตร์ชีวภาพวีถีไทย คณะวิทยาศาสตร์และเทคโนโลยี ร่วมกับ สถาบันสุขภาพผิวฟีโอน่า ได้จัดอบรมเชิงปฏิบัติการ "ความปลอดภัยด้าน จุลินทรีย์ในสภาพแวดล้อมของสถานประกอบการ เวลเนส และ ความงาม แบบมืออาชีพ"
หลักสูตร วิทยาศาสตร์ชีวภาพวีถีไทย คณะวิทยาศาสตร์และเทคโนโลยี ร่วมกับ สถาบันสุขภาพผิวฟีโอน่า
ได้จัดอบรมเชิงปฏิบัติการ "ความปลอดภัยด้าน จุลินทรีย์ในสภาพแวดล้อมของสถานประกอบการ เวลเนส และ ความงาม แบบมืออาชีพ"
วันที่ 13-14 พฤศจิกายน 2568 เวลา 08.30 - 16.30 น.
ณ ห้องประชุมราชพฤกษ์ คณะวิทยาศาสตร์และเทคโนโลยี
มหาวิทยาลัยราชภัฏวไลยอลงกรณ์ ในพระบรมราชูปถัมภ์ จังหวัดปทุมธานี